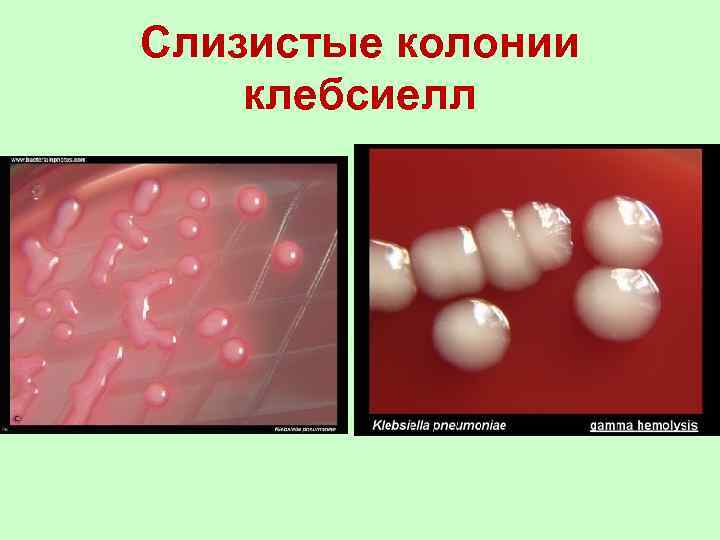
Слизистые колонии клебсиелл
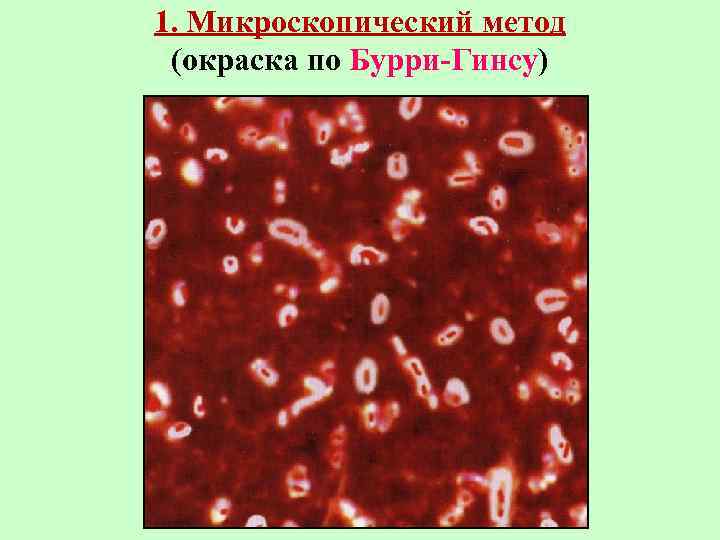
1. Микроскопический метод (окраска по Бурри-Гинсу)
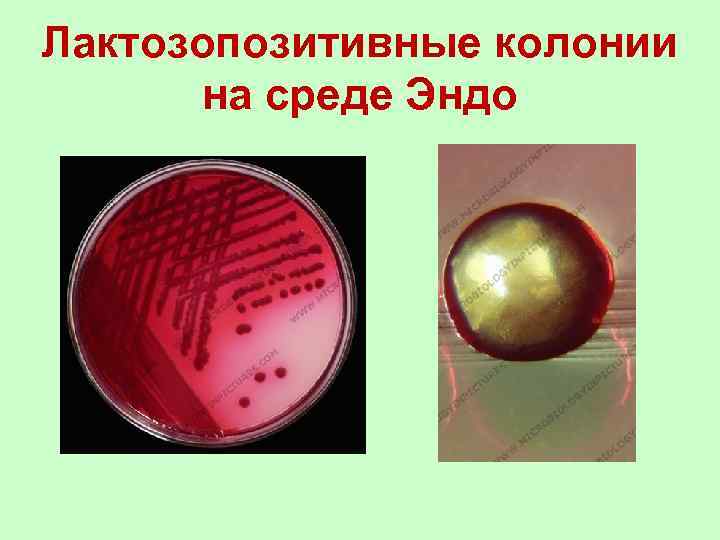
Лактозопозитивные колонии на среде Эндо

Клебсиеллы, протей, сан. микроб..ppt
- Количество слайдов: 41

КЛЕБСИЕЛЛЫ

КЛАССИФИКАЦИЯ 5 группа по Берджи – факультативно-анаэробные Грампалочки Семейство: Enterobacteriaceae Род: Klebsiella Виды: K. oxytoca K. planticola K. terrigena K. pneumoniae : §Подвиды: §K. pneumoniae §K. rhinoscleromatis §K. ozenae

Морфологические и тинкториальные свойства • Толстые короткие палочки с закругленными концами • Располагаются попарно или поодиночке • Грамотрицательные • Спор не образуют • Неподвижны • Имеют выраженную капсулу

Культуральные свойства • Факультативные анаэробы • Хорошо растут на простых питательных средах • Колонии на агаре круглые, пышные, часто сливающиеся друг с другом, мутные, слизистые • Рост на бульоне в виде диффузного помутнения (иногда – со слизистой плёнкой на поверхности) • Температурный оптимум для роста (мезофилы), оптимальная р. Н 7, 2 – 7, 4 +37°С
Слизистые колонии клебсиелл

Антигенные свойства • О-АГ – 11 сероваров • К-АГ – 82 серовара • Желатин не разжижают • НЕ образуют индол и H 2 S

Заболевания, вызываемые клебсиеллами Первоначально K. pneumoniae была определена, как микроорганизм вызывающий пневмонию (отсюда и ее название). Однако её роль не сводится только к инфекциям респираторной системы. K. pneumoniae классифицируется как условно-патогенный микроб, находящийся в норме и в определенных органах (например, в кишечнике) в симбиотическом отношении с человеческим организмом, а в иных ситуациях являющийся причиной инфекционных заболеваний. K. pneumoniae — один из возбудителей внутрибольничных инфекций, чаще всего мочевыводящих путей, мозговых оболочек, суставов, могут вызывать сепсис и гнойные послеоперационные осложнения. В молочных продуктах клебсиеллы могут размножаться даже при хранении в холодильнике и могут вызывать пищевые токсикоинфекции. K. ozaenae вызывает озену - хронический атрофический ринит (зловонный насморк). K. rhinoscleromatis вызывает риносклерому - хроническое гранулематозное заболевание дыхательных путей, поражает глотку, гортань, трахею.

Факторы патогенности клебсиелл • Факторы адгезии и колонизации: – пили – белки наружной мембраны – полисахариды капсулы • Защита клебсиелл от фагоцитоза (агрессины) – полисахариды капсулы – К-АГ • Эндотоксин ЛПС • Экзотоксин энтеротоксин стимулирует активность аденилатциклазы и отвечает за развитие диареи

Эпидемиология клебсиеллёзных инфекций • Источник при внутрибольничных инфекциях – человек больной или бактерионоситель. Может быть экзо - и эндогенное заражение • Пути передачи: 1. воздушно-капельный 2. алиментарный (пищевой) 3. контактный • Восприимчивый коллектив – любой человек. При внутрибольничных инфекциях – человек со сниженным иммунитетом

Лабораторная диагностика Исследуемый материал: зависит от клиники и локализации: мокрота, слизь испражнения, моча, ликвор, отделяемое, кровь и т. д. Методы диагностики: 1. Микроскопический 2. Бактериологический 3. Серологический из носа, гнойное
1. Микроскопический метод (окраска по Бурри-Гинсу)

2. Бактериологический метод - основной Посев производят на: 1. дифференциально-диагностическую среду К-2 (с мочевиной, рафинозой и бромтимоловым синим) Колонии K. pneumoniae, выделяющей уреазу и расщепляющей мочевину, - голубые, а клебсиелл, не имеющих уреазы, - желтые 2. дифференциально-диагностическую среду с лактозой и бромтимоловым синим Колонии сочные и блестящие, цвет колоний клебсиелл, не расщепляющих лактозу, - голубой, а лактозопозитивные колонии K. pneumoniae желтого цвета 3. среду Эндо – лактозонегативные колонии – бесцветные, лактозопозитивные – красные с металлическим блеском. Из подозрительных колоний делают мазки, окрашивают их по Граму и Бури-Гинсу и пересевают на скошенный агар или среду Ресселя для получения чистой культуры. Идентификацию чистой культуры проводят по: 1. Биохимическим свойствам 2. Антигенным свойствам: используют РА с агглютинирующими К-сыворотками
Лактозопозитивные колонии на среде Эндо

3. Серологический метод. 1. РСК с О-антигеном клебсиелл (с химическим склеромным диагностикумом) 2. РА с бактериальным диагностикумом Диагностически значимо четырехкратное увеличение титра АТ в динамике

Специфическое лечение Бактериофаг клебсиеллёзный поливалетный Пиобактериофаг

ПРОТЕЙ

КЛАССИФИКАЦИЯ 5 группа по Берджи – факультативно-анаэробные Грампалочки Семейство: Enterobacteriaceae Род: Proteus Виды: P. vulgaris P. mirabilis • Ранее относящиеся к роду Proteus бактерии вида Proteus morganii перенесены в род Morganella morganii семейства энтеробактерий, а Proteus rettgeri классифицированы в Providencia rettgeri.

Морфологические и тинкториальные свойства • Мелкие палочки с закруглёнными концами • Грамотрицательные • Спор не образуют • Капсулы не имеют • Имеют жгутики (перитрихи) • Встречаются неподвижные формы (О-формы)

Культуральные свойства • Факультативные анаэробы • Хорошо растут на простых питательных средах • На плотных питательных средах дают феномен роения – ползучий рост в виде нежной вуали голубовато-дымчатого цвета • Для выявления ползучего роста используют посев по Шукевичу (в конденсационную воду у основания скошенного агара) • Рост на бульоне в виде диффузного помутнения с густым белым осадком на дне • Температурный оптимум для роста 37°С (мезофилы), оптимальная р. Н 7, 2 – 7, 4

Ползучий рост протея

Антигенные свойства • О-АГ – 49 сероваров • Н-АГ – 19 сероваров Биохимические свойства • Протеи продуцируют фермент фенилаланиндезаминазу и дезаминируют фенилаланин до фенил-пировиноградной кислоты

Заболевания, вызываемые протеем • Являются условно-патогенными микроорганизмами. • Могут вызывать пищевые токсикоинфекции • Наиболее часто острые кишечные инфекции, вызываемые протеем, встречаются у детей раннего возраста: ослабленных или с пониженным иммунитетом. • Являются возбудителями внутрибольничных (госпитальных) инфекций: вызывают инфекции мочевыводящих путей, вторичные септические поражения у пациентов с ожогами и после хирургических вмешательств, пневмонию, менингит и др.

Факторы патогенности протея • Факторы адгезии и колонизации: – пили – белки наружной мембраны • Ферменты патогенности: – Уреаза – Протеазы, разрушающие Ig. A • Эндотоксин - ЛПС

Лабораторная диагностика Исследуемый материал: зависит от клиники и локализации: моча, гнойное отделяемое, кровь, ликвор, промывные воды желудка, мокрота и т. д. Метод диагностики: бактериологический

Бактериологический метод Посев производят на: 1. Среду Плоскирева Протей образует лактозонегативные колонии 2. Скошенный агар с фенилаланином к культуре на среде с фенилаланином добавляют 10 - 12 капель 10% раствора хлорного железа (Fе. Сl 3 х 6 Н 2 О). При положительной реакции на фенилаланиндезаминазу через 2 -3 мин. культура окрашивается в зелено-синий цвет, при отрицательной реакции цвет культуры не изменяется. Для выявления ползучего роста используют посев по Шукевичу (в конденсационную воду у основания скошенного агара). Идентификацию чистой культуры проводят по: 1. Культуральным свойствам 2. Биохимическим свойствам 3. Антигенным свойствам: используют РА с агглютинирующими О-сыворотками и Нсыворотками

Специфическое лечение Бактериофаг колипротейный Бактериофаг протейный Интестибактериофаг

Санитарная микробиология

• Санитарная микробиология – направление медицинской микробиологии, изучающее микрофлору окружающей среды и ее влияние на здоровье человека и на состояние среды его обитания. • Задачи санитарной микробиологии: микробиологии – Исследование объектов внешней среды (воздух, почва, вода) для оценки их воздействия на здоровье человека. – Обследование здоровых лиц (работников пищевых, детских, лечебных учреждений) на носительство патогенных микроорганизмов. – Исследование пищевых продуктов с целью их гигиенической характеристики и эпидемиологической оценки; проведение специальных анализов на наличие патогенных микробов при пищевых отравлениях. – Контроль за дезинфекционными мероприятиями.

Принципы проведения санитарномикробиологических исследований • Пробы отбирают с соблюдением всех условий, регламентированных для каждого исследуемого объекта. • Исследования проводят быстро; допускается хранение материала в холодильнике не дольше 6 - 8 часов. • Для получения объективных результатов отбирают несколько проб из разных участков объекта, а также проводят повторные отборы и анализы проб. • Используют только стандартные и унифицированные методы исследования. • В работе используют комплекс тестов: а) прямые – выявляют патогенные микроорганизмы, б) косвенные – указывают на загрязнение объектов окружающей среды выделениями человека и животных. • Интерпретацию результатов санитарномикробиологических исследований проводят с учетом других гигиенических показателей (химических, физических, органолептических и др. ).

Методы санитарной микробиологии • Прямая и люминесцентная микроскопия • Бактериологический метод • Биологический метод (в основном для определения токсинов) • Микологические методы • Вирусологические методы

Проведение санитарномикробиологических исследований направлено на: • Определение общего микробного числа (ОМЧ) исследуемого объекта; • Определение и титрование санитарно-показательных микроорганизмов (СПМ) в исследуемом объекте; • Выявление в исследуемых объектах патогенных микроорганизмов

• Общее микробное число (ОМЧ) – это общее количество микроорганизмов в единице объема или массы исследуемого объекта (в 1 мл или в 1 г). • Чем выше ОМЧ объекта, тем выше возможность присутствия в нём патогенных микроорганизмов. • Методы определения ОМЧ: - прямой подсчет бактерий в счетных камерах с помощью обычного или фазово-контрастного микроскопа, - количественный посев на плотные питательные среды.

Определение ОМЧ воздуха • Проводится в закрытых помещениях • Используют: – седиментационный метод открытые чашки Петри со стерильной питательной средой расставляют в помещении. Бактерии из воздуха оседают на поверхность среды, затем чашки закрывают, инкубируют и подсчитывают количество выросших колоний.

– аспирационный метод Используют специальные аппараты, например, аппарат Кротова. ОМЧ определяют в 100 л воздуха. Посев воздуха осуществляется через отверстие в отсеке на чашку Петри с питательной средой, закрепленную на вращающемся столике прибора. Прокачка воздуха осуществляется с помощью встроенного в прибор пневмонасоса. Скорость протягивания воздуха 25 л/мин. Затем инкубируют посевы и подсчитывают число колоний. • Нормы ОМЧ регламентированы для воздуха различных помещений.

Аппарат Кротова

Санитарно-показательные микроорганизмы (СПМ) - это микроорганизмы, указывающие на загрязнение внешней среды выделениями человека или животных. • Присутствие СПМ в объекте внешней среды указывает на возможность наличия в этом объекте других, в т. ч. патогенных для человека, микроорганизмов, непосредственное обнаружение которых затруднено. • СПМ являются постоянные обитатели естественных полостей человека или животных, которые постоянно выделяются в окружающую среду.

СПМ делят на 3 группы: • группа А включает обитателей кишечника человека и животных, их расценивают как индикаторы фекального загрязнения (эшерихии, энтерококки, протеи, клостридии и др. ), • группа В включает обитателей верхних дыхательных путей, их расценивают как индикаторы путей орального загрязнения (стрептококки, стафилококки), • группа С включает сапрофитические микроорганизмы, микроорганизмы обитающие во внешней среде, их расценивают как индикаторы процессов самоочищения (бактерии-аммонификаторы, бактерии-нитрификаторы и др. ).

СПМ различных объектов внешней среды Исследуемые объекты СПМ • Вода • Бактерии группы кишечной палочки (БГКП) • Энтерококки • Почва • БГКП • Энтерококки • Анаэробы группы Clostridium perfringens • Воздух • Стрептококки • Стафилококки • Пищевые продукты • • • Предметы обихода БГКП Энтерококки Стафилококки Протей • БГКП • Энтерококки • Стафилококки

При количественном определении СПМ результаты исследований выражаются в 2 величинах: 1. Индекс СПМ (например, коли-индекс) коли-индекс - это количество СПМ, обнаруженное в единице объема или массы исследуемого объекта. Для определения индекса СПМ используют: 1) метод мембранных фильтров 2) метод бродильных проб 2. Титр СПМ (например, коли-титр) коли-титр - это наименьшее количество исследуемого объекта, в котором обнаружена хотя бы одна особь СПМ.

• Сущность метода мембранных фильтров заключается в фильтровании определенных объемов исследуемой жидкости (или твердого вещества, разведенного в воде) через мембранные фильтры, на которых задерживаются бактерии. • Фильтры переносят на чашки со средой Эндо, инкубируют при + 37°. • Подсчитывают выросшие на фильтре колонии кишечной палочки и проводят перерасчет на 1 л, 1 кг или 1 г в зависимости от исследуемого материала. • Сущность метода бродильных проб заключается в посеве определенных объемов исследуемого субстрата на глюкозопептонную среду с индикатором и поплавком (для определения ферментации глюкозы), которые выдерживают при + 37°. Из всех помутневших пробирок делают высевы на среду Эндо с последующей идентификацией и подсчётом выросших колоний. • Коли-титр — величина, обратная коли-индексу.

Патогенные микроорганизмы (ПМ) • Обнаружение ПМ в объектах внешней среды производится: – путем прямого посева на питательные среды – путем посева после предварительной концентрации микроорганизмов с помощью фильтрации, центрифугирования, осаждения коагулянтами и т. д. • Идентификация ПМ производится согласно общепринятым схемам. • Согласно ГОСТу: “патогенные микроорганизмы и их токсины должны отсутствовать в питьевой воде и пищевых продуктах”.
Клебсиеллы, протей, сан. микроб..ppt